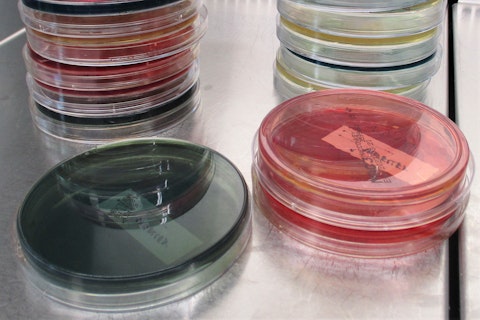
Platten Glass Cylinder

Our new experimental station for Crop Science is based in Benacazón, Seville. Situated in the heart of Spanish agriculture, it's fully equipped with for a range of crop-focused experiments.

From October 2022, SGS's Brookings laboratory in South Dakota will provide key plant genotyping services.

SGS can now analyze the impact of biostimulants, pesticides and seed treatment solutions on the soil microbiome community.